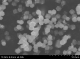
金属有机骨架化合物（Metal Organic Framework）-Zeolitic Imidazolate Framework-67 (ZIF-67)

详情
1. 制备方法
A型:溶剂热法
B型:溶剂热法+干燥150摄氏度(8小时)
2. 表征
A型:
形态:金属有机骨架(MOFs)
外观:粉紫色
粒径:150-400 nm
BET比表面积(m2/g):~316(参考值)
质量:5g
B型:
形态:金属有机骨架(MOF)
外观:粉紫色
粒径:1.7 um
BET比表面积(m2/g):~233(参考值)
质量:5g

Typical SEM Image of ACS Material ZIF-67 (Type A)

Typical SEM Image of ACS Material ZIF-67 (Type B)

XRD Analysis of ACS Material ZIF-67
Update Required
To play the media you will need to either update your browser to a recent version or update your Flash plugin.

陈谷一
陈谷一